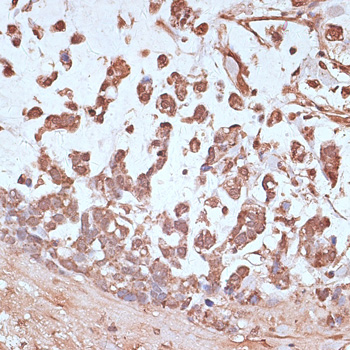

-
Product Name
NFE2L1 Polyclonal Antibody
- Documents
-
Description
Polyclonal antibody to NFE2L1
-
Tested applications
WB, IHC, IF
-
Species reactivity
Human, Mouse, Rat
-
Alternative names
NFE2L1 antibody; LCR-F1 antibody; NRF1 antibody; TCF11 antibody; nuclear factor, erythroid 2 like 1 antibody
-
Isotype
Rabbit IgG
-
Preparation
Antigen: Recombinant fusion protein containing a sequence corresponding to amino acids 515-772 of human NFE2L1 (NP_003195.1).
-
Clonality
Polyclonal
-
Formulation
PBS with 0.02% sodium azide, 50% glycerol, pH7.3.
-
Storage instructions
Store at -20℃. Avoid freeze / thaw cycles.
-
Applications
WB 1:500 - 1:2000
IHC 1:50 - 1:200
IF 1:50 - 1:200 -
Validations

Western blot - NFE2L1 Polyclonal Antibody
Western blot analysis of extracts of various cell lines, using NFE2L1 antibody at 1:1000 dilution.Secondary antibody: HRP Goat Anti-Rabbit IgG (H+L) at 1:10000 dilution.Lysates/proteins: 25ug per lane.Blocking buffer: 3% nonfat dry milk in TBST.Detection: ECL Basic Kit .Exposure time: 1s.

Immunohistochemistry - NFE2L1 Polyclonal Antibody
Immunohistochemistry of paraffin-embedded rat spleen using NFE2L1 antibody at dilution of 1:100 (40x lens).

Immunohistochemistry - NFE2L1 Polyclonal Antibody
Immunohistochemistry of paraffin-embedded rat heart using NFE2L1 antibody at dilution of 1:100 (40x lens).

Immunohistochemistry - NFE2L1 Polyclonal Antibody
Immunohistochemistry of paraffin-embedded human lung cancer using NFE2L1 antibody at dilution of 1:100 (40x lens).

Immunohistochemistry - NFE2L1 Polyclonal Antibody
Immunohistochemistry of paraffin-embedded human colon using NFE2L1 antibody at dilution of 1:100 (40x lens).

Immunohistochemistry - NFE2L1 Polyclonal Antibody
Immunohistochemistry of paraffin-embedded human placenta using NFE2L1 antibody at dilution of 1:100 (40x lens).
Immunohistochemistry - NFE2L1 Polyclonal Antibody
Immunohistochemistry of paraffin-embedded human gastric cancer using NFE2L1 antibody at dilution of 1:100 (40x lens).

Immunohistochemistry - NFE2L1 Polyclonal Antibody
Immunohistochemistry of paraffin-embedded human uterus using NFE2L1 antibody at dilution of 1:100 (40x lens).

Immunohistochemistry - NFE2L1 Polyclonal Antibody
Immunohistochemistry of paraffin-embedded mouse brain using NFE2L1 antibody at dilution of 1:100 (40x lens).

Immunofluorescence - NFE2L1 Polyclonal Antibody
Immunofluorescence analysis of HeLa cells using NFE2L1 antibody at dilution of 1:100. Blue: DAPI for nuclear staining.
-
Background
Endoplasmic reticulum membrane sensor NFE2L1: Endoplasmic reticulum membrane sensor that translocates into the nucleus in response to various stresses to act as a transcription factor. Constitutes a precursor of the transcription factor NRF1 (By similarity). Able to detect various cellular stresses, such as cholesterol excess, oxidative stress or proteasome inhibition. In response to stress, it is released from the endoplasmic reticulum membrane following cleavage by the protease DDI2 and translocates into the nucleus to form the transcription factor NRF1 (By similarity). Acts as a key sensor of cholesterol excess: in excess cholesterol conditions, the endoplasmic reticulum membrane form of the protein directly binds cholesterol via its CRAC motif, preventing cleavage and release of the transcription factor NRF1, thereby allowing expression of genes promoting cholesterol removal, such as CD36 (By similarity). Involved in proteasome homeostasis: in response to proteasome inhibition, it is released from the endoplasmic reticulum membrane, translocates to the nucleus and activates expression of genes encoding proteasome subunits.; Transcription factor NRF1: CNC-type bZIP family transcription factor that translocates to the nucleus and regulates expression of target genes in response to various stresses. Heterodimerizes with small-Maf proteins (MAFF, MAFG or MAFK) and binds DNA motifs including the antioxidant response elements (AREs), which regulate expression of genes involved in oxidative stress response. Activates or represses expression of target genes, depending on the context. Plays a key role in cholesterol homeostasis by acting as a sensor of cholesterol excess: in low cholesterol conditions, translocates into the nucleus and represses expression of genes involved in defense against cholesterol excess, such as CD36 (By similarity). In excess cholesterol conditions, the endoplasmic reticulum membrane form of the protein directly binds cholesterol via its CRAC motif, preventing cleavage and release of the transcription factor NRF1, thereby allowing expression of genes promoting cholesterol removal (By similarity). Critical for redox balance in response to oxidative stress: acts by binding the AREs motifs on promoters and mediating activation of oxidative stress response genes, such as GCLC, GCLM, GSS, MT1 and MT2 (By similarity). Plays an essential role during fetal liver hematopoiesis: probably has a protective function against oxidative stress and is involved in lipid homeostasis in the liver (By similarity). Involved in proteasome homeostasis: in response to proteasome inhibition, mediates the 'bounce-back' of proteasome subunits by translocating into the nucleus and activating expression of genes encoding proteasome subunits. Also involved in regulating glucose flux (By similarity). Together with CEBPB; represses expression of DSPP during odontoblast differentiation. In response to ascorbic acid induction, activates expression of SP7/Osterix in osteoblasts.
Related Products / Services
Please note: All products are "FOR RESEARCH USE ONLY AND ARE NOT INTENDED FOR DIAGNOSTIC OR THERAPEUTIC USE"
